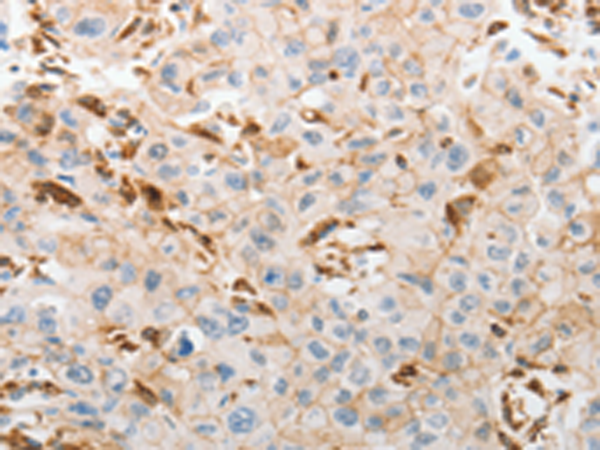
一抗

中文名稱:兔抗SLC15A2多克隆抗體
儲(chǔ) 存: 冷凍(-20℃)
反應(yīng)種屬: Human
克隆類型: rabbit polyclonal
技術(shù)規(guī)格
|
Background: |
The mammalian kidney expresses a proton-coupled peptide transporter that is responsible for the absorption of small peptides, as well as beta-lactam antibiotics and other peptide-like drugs, from the tubular filtrate. This transporter, SLC15A2, belongs to the same gene family as SLC15A1 (MIM 600544), the proton-coupled peptide transporter found in the small intestine |
|
Applications: |
ELISA, IHC |
|
Name of antibody: |
SLC15A2 |
|
Immunogen: |
Synthetic peptide of human SLC15A2 |
|
Full name: |
solute carrier family 15 (H+/peptide transporter), member 2 |
|
Synonyms: |
PEPT2 |
|
SwissProt: |
Q16348 |
|
ELISA Recommended dilution: |
2000-5000 |
|
IHC positive control: |
Human lung cancer |
|
IHC Recommend dilution: |
50-200 |

 購物車
購物車 幫助
幫助
 021-54845833/15800441009
021-54845833/15800441009